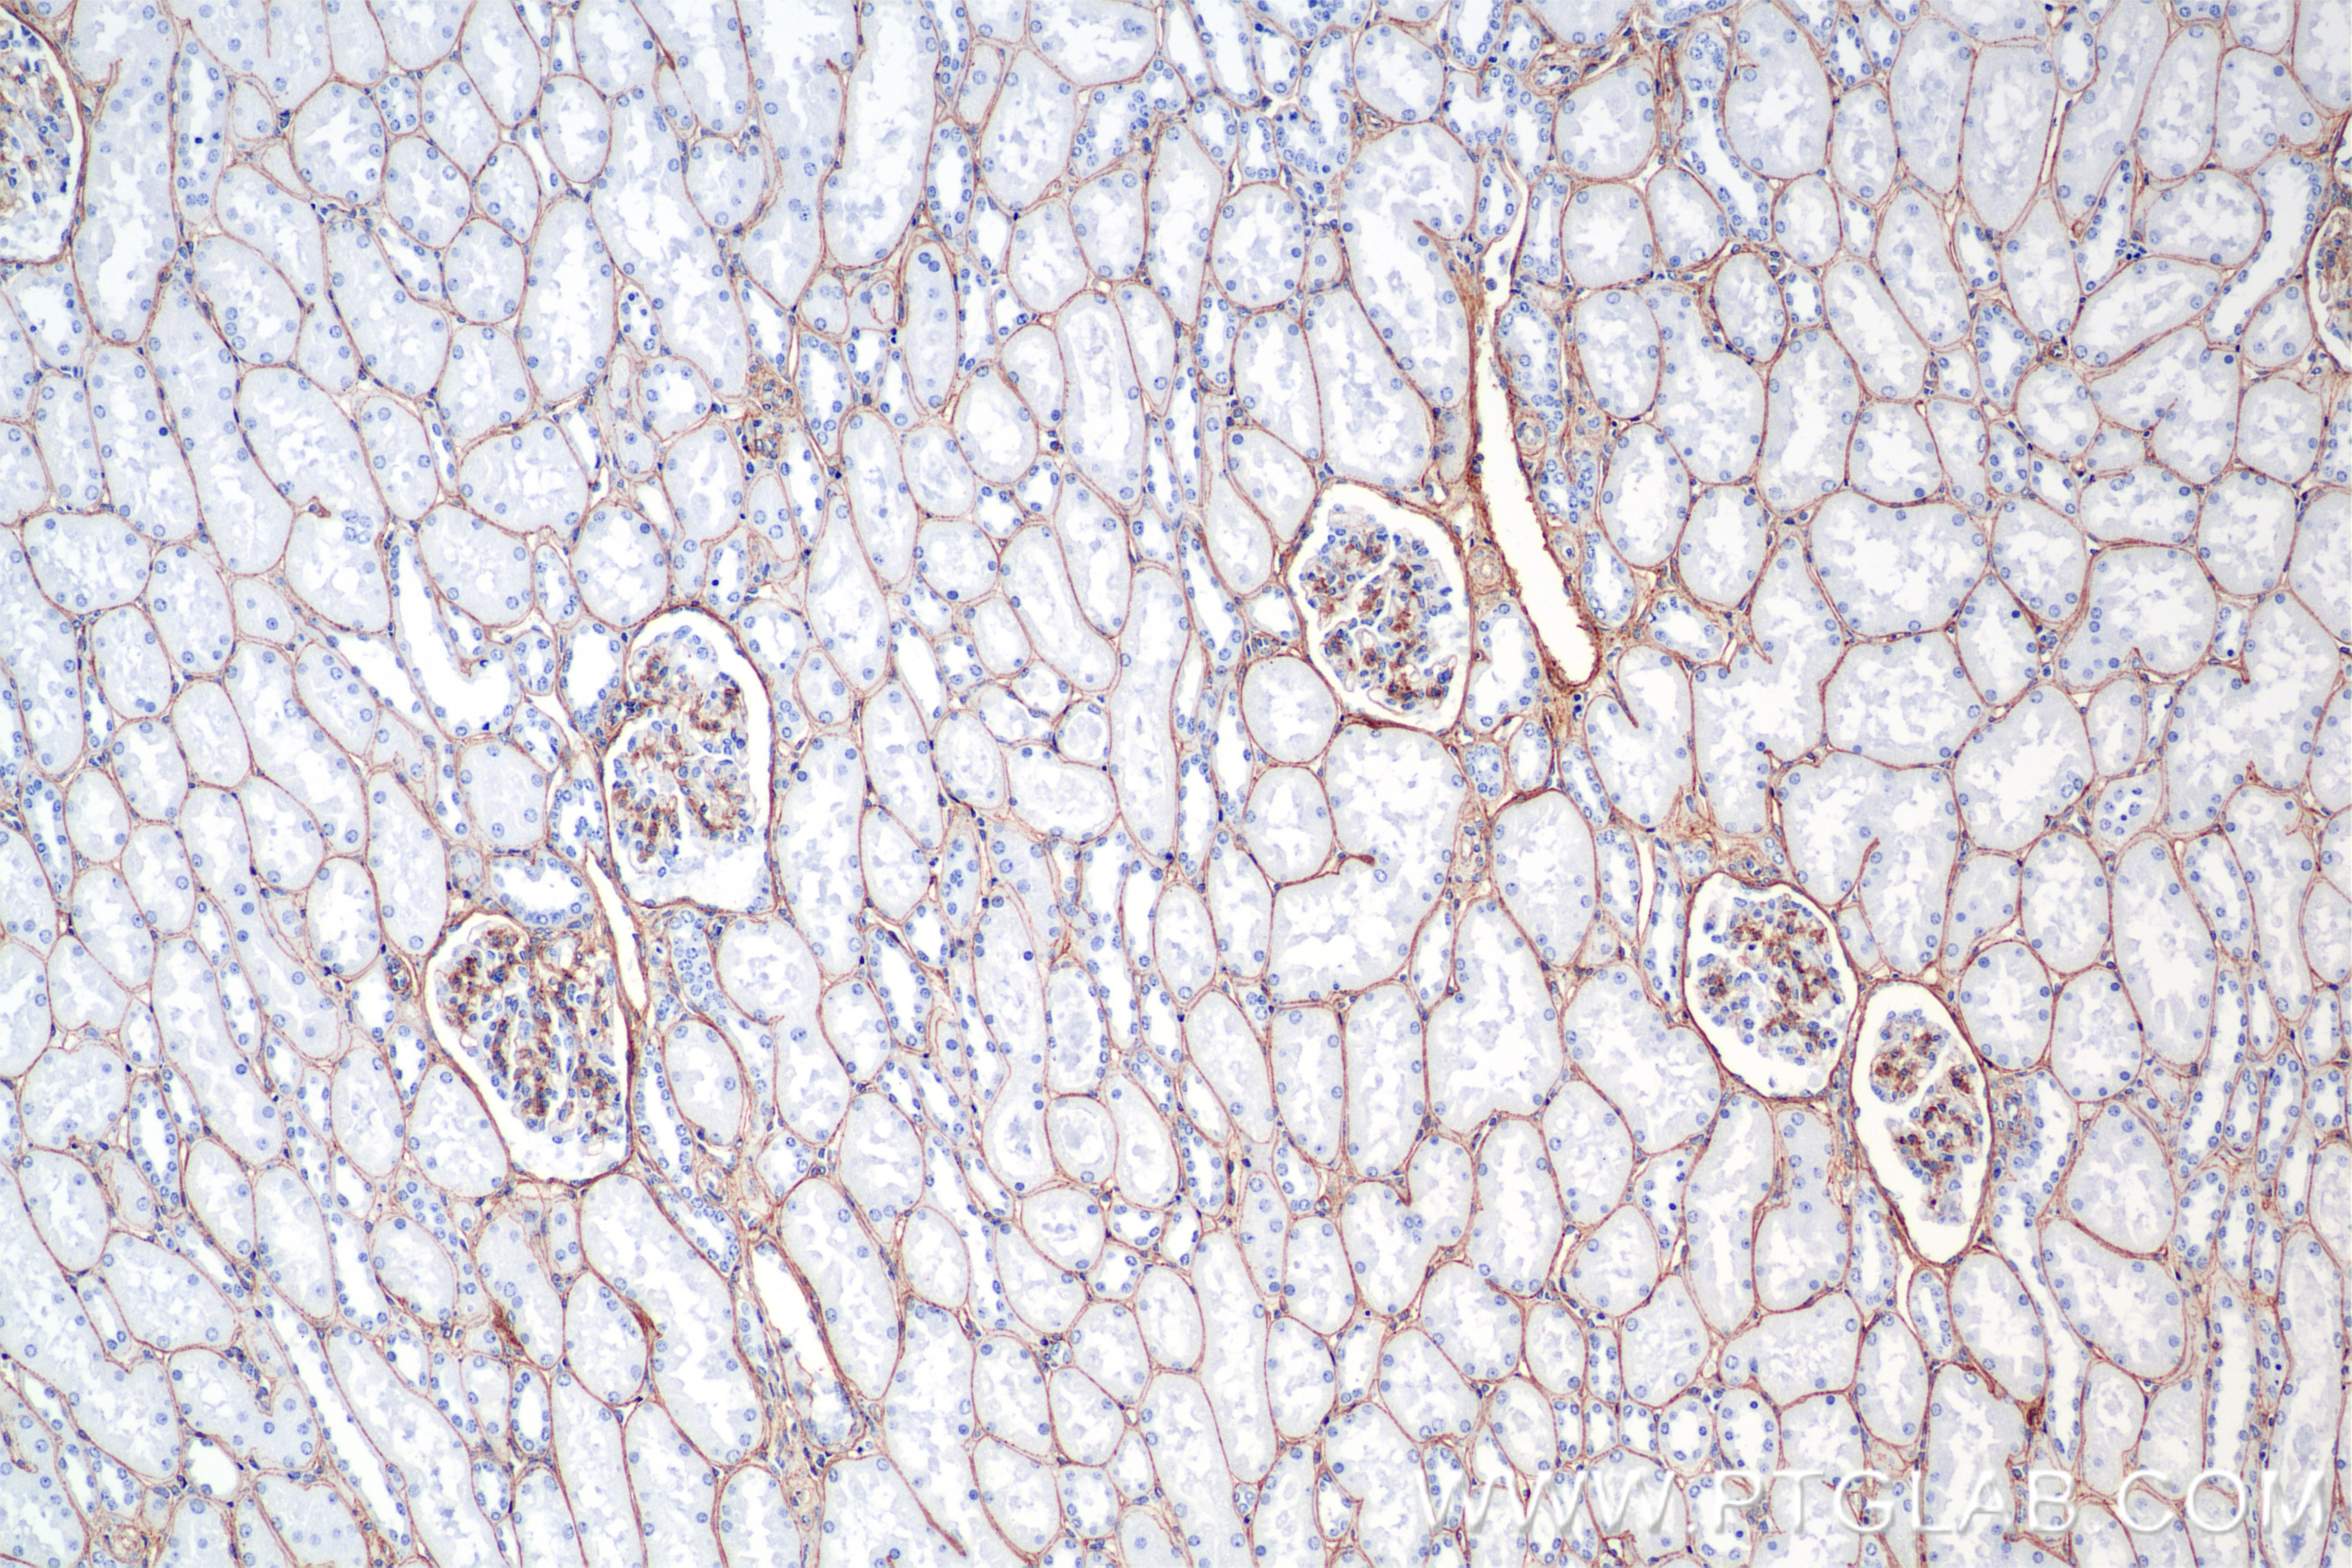
Immunohistochemical analysis of paraffin-embedded human kidney tissue slide using <a class='green' href='/productredirect?CatalogNo=85256-4-RR' target='_blank'>85256-4-RR</a> (COL4A1 antibody) at dilution of 1:1500 (under 10x lens). Heat mediated antigen retrieval with Tris-EDTA buffer (pH 9.0). This data was developed using the same antibody clone with 85256-4-PBS in a different storage buffer formulation. IHC staining of human kidney using 85256-4-RR (same clone as 85256-4-PBS)

验证数据展示
产品信息
85256-4-PBS targets COL4A1 in WB, IHC, Indirect ELISA applications and shows reactivity with human samples.
| 经测试应用 | WB, IHC, Indirect ELISA Application Description |
| 经测试反应性 | human |
| 免疫原 |
CatNo: Ag34391 Product name: Recombinant human COL4A1 protein Source: e coli.-derived, PGEX-4T Tag: GST Domain: 901-1110 aa of BC151220 Sequence: LPGEKGDHGFPGSSGPRGDPGLKGDKGDVGLPGKPGSMDKVDMGSMKGQKGDQGEKGQIGPIGEKGSRGDPGTPGVPGKDGQAGQPGQPGPKGDPGISGTPGAPGLPGPKGSVGGMGLPGTPGEKGVPGIPGPQGSPGLPGDKGAKGEKGQAGPPGIGIPGLRGEKGDQGIAGFPGSPGEKGEKGSIGIPGMPGSPGLKGSPGSVGYPGS 种属同源性预测 |
| 宿主/亚型 | Rabbit / IgG |
| 抗体类别 | Recombinant |
| 产品类型 | Antibody |
| 全称 | collagen, type IV, alpha 1 |
| 别名 | arresten, Collagen alpha 1(IV) chain, Collagen alpha-1(IV) chain, Collagen Type IV |
| 计算分子量 | 1669 aa, 161 kDa |
| 观测分子量 | 220 kDa |
| GenBank蛋白编号 | BC151220 |
| 基因名称 | COL4A1 |
| Gene ID (NCBI) | 1282 |
| 偶联类型 | Unconjugated |
| 形式 | Liquid |
| 纯化方式 | Protein A purification |
| UNIPROT ID | P02462 |
| 储存缓冲液 | PBS only, pH 7.3. |
| 储存条件 | Store at -80°C. The product is shipped with ice packs. Upon receipt, store it immediately at -80°C |
背景介绍
COL4A1 (Collagen Type IV Alpha 1 Chain) encodes a major component of type IV collagen, which is an essential structural element of basement membranes in various tissues. COL4A1 forms heterotrimers with other collagen type IV chains (e.g., COL4A2) and interacts with extracellular matrix components such as laminins, proteoglycans, and perlecans. Proteolytic cleavage of the non-collagenous domain of COL4A1 produces a fragment called arresten, which has anti-angiogenic and tumor suppressor properties. Elevated expression of COL4A1 has been observed in various cancers, including hepatocellular carcinoma (HCC), where it promotes tumor growth and metastasis through the FAK-Src signaling pathway. COL4A1 is highly expressed in various tissues, including the placenta, fat, and other organs. The expression of COL4A1 can be regulated by transcription factors such as RUNX1, which has been shown to upregulate COL4A1 in hepatocellular carcinoma.